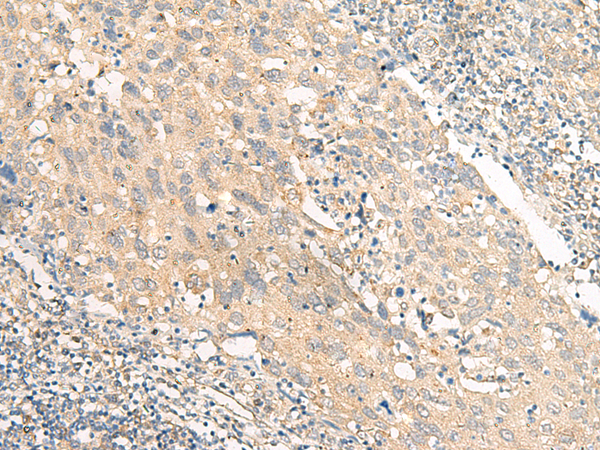
一抗

中文名稱:兔抗CHP1多克隆抗體
|
Background: |
This gene encodes a phosphoprotein that binds to the Na+/H+ exchanger NHE1. This protein serves as an essential cofactor which supports the physiological activity of NHE family members and may play a role in the mitogenic regulation of NHE1. The protein shares similarity with calcineurin B and calmodulin and it is also known to be an endogenous inhibitor of calcineurin activity. |
|
Applications: |
ELISA, IHC |
|
Name of antibody: |
CHP1 |
|
Immunogen: |
Synthetic peptide of human CHP1 |
|
Full name: |
calcineurin like EF-hand protein 1 |
|
Synonyms: |
CHP; p22; p24; Sid470p; SLC9A1BP |
|
SwissProt: |
Q99653 |
|
ELISA Recommended dilution: |
5000-10000 |
|
IHC positive control: |
Human cervical cancer and Human lung cancer |
|
IHC Recommend dilution: |
30-150 |


 購(gòu)物車
購(gòu)物車 幫助
幫助
 021-54845833/15800441009
021-54845833/15800441009